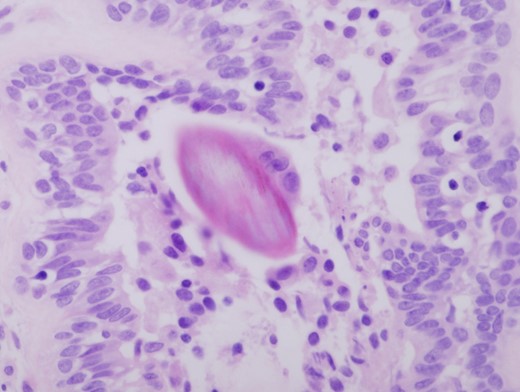
Hair shaft material in a duct with associated chronic inflammation (HE ×400).

-
PDF
- Split View
-
Views
-
Cite
Cite
Rashmi Lahiri, Russell Mullen, Mark A. Ashton, Nick C. Abbott, Anne Marie Pollock, Pilonidal abscess in the breast: a case report, Journal of Surgical Case Reports, Volume 2014, Issue 6, June 2014, rju061, https://doi.org/10.1093/jscr/rju061
Close - Share Icon Share
Abstract
Pilonidal sinus is a common entity, most often occurring in the natal cleft. Pilonidal sinus with abscess formation has also been described in hairdressers in the interdigital space. We report a case of pilonidal abscess of the breast in a hairdresser, a rarely reported site, which requires awareness on the clinician's part of this occupational risk, for appropriate management and post-surgery advice on prevention. It is particularly important to impart such information to the reporting pathologist who is key to making this histological diagnosis.
INTRODUCTION
Pilonidal sinus is a common lesion, most often seen in the natal cleft. Other sites include the axilla, umbilicus, ear, nose, finger and toe web spaces. It is a well-recognized occupational hazard of male barbers being rare in sheep-shearers and dog groomers [1]. It is relatively uncommon in female hairdressers and largely confined to the finger or toe web spaces.
CASE REPORT
A 28-year-old woman presented acutely to the general surgery team with a 4-week history of a left breast non-lactational abscess. She was a smoker, but her past medical history was unremarkable. A diagnosis of acute abscess secondary to periductal mastitis was made by the surgical team. Ultrasound examination showed multiple periareolar collections up to 2 cm in size. The content of the collection was too thick to aspirate necessitating incision and drainage. Cavity biopsies were taken at the time and these showed inflammatory changes only. Culture was positive for a Group C Haemolytic streptococcus and mixed anaerobes. Subsequent wound healing was satisfactory despite a rather protracted course.
The patient re-presented 5 months later with two further episodes of breast sepsis at the same site which failed to settle with conservative treatment. After discussion, total duct excision was carried out in an attempt to resolve the chronic sepsis. Histological examination showed benign breast tissue with evidence of acute and chronic inflammation in association with micro-abscess formation (Fig. 1). Further sections showed hair shaft material within a duct and associated active chronic inflammation (Fig. 2), demonstrating the pilonidal nature of the breast sepsis. Subsequent discussion with the surgeon revealed the patient to be a hairdresser. Review of the first set of biopsies identified some possible hair shaft material, but this was not conclusive. On post-operative review the patient is well with no further episodes of sepsis.

Granulation tissue and micro abscess formation in total duct excision specimen (HE ×200).
Hair shaft material in a duct with associated chronic inflammation (HE ×400).
DISCUSSION
Pilonidal disease is of course commonly seen in the natal cleft and is well recognized in the inter-digital space [2, 3]. Pilonidal disease of the periareolar area is a rarely reported occupational hazard of hairdressers [4–6]. This case highlights the importance for breast surgeons to be aware of the occupation of non-lactational breast sepsis patients. When operative intervention is required, this information should be imparted to pathologists so that a diligent search of the specimen for hair shaft material is made. The correct diagnosis is not only important for surgical management, in this case total duct excision, but also in counselling the patient to prevent a recurrence.